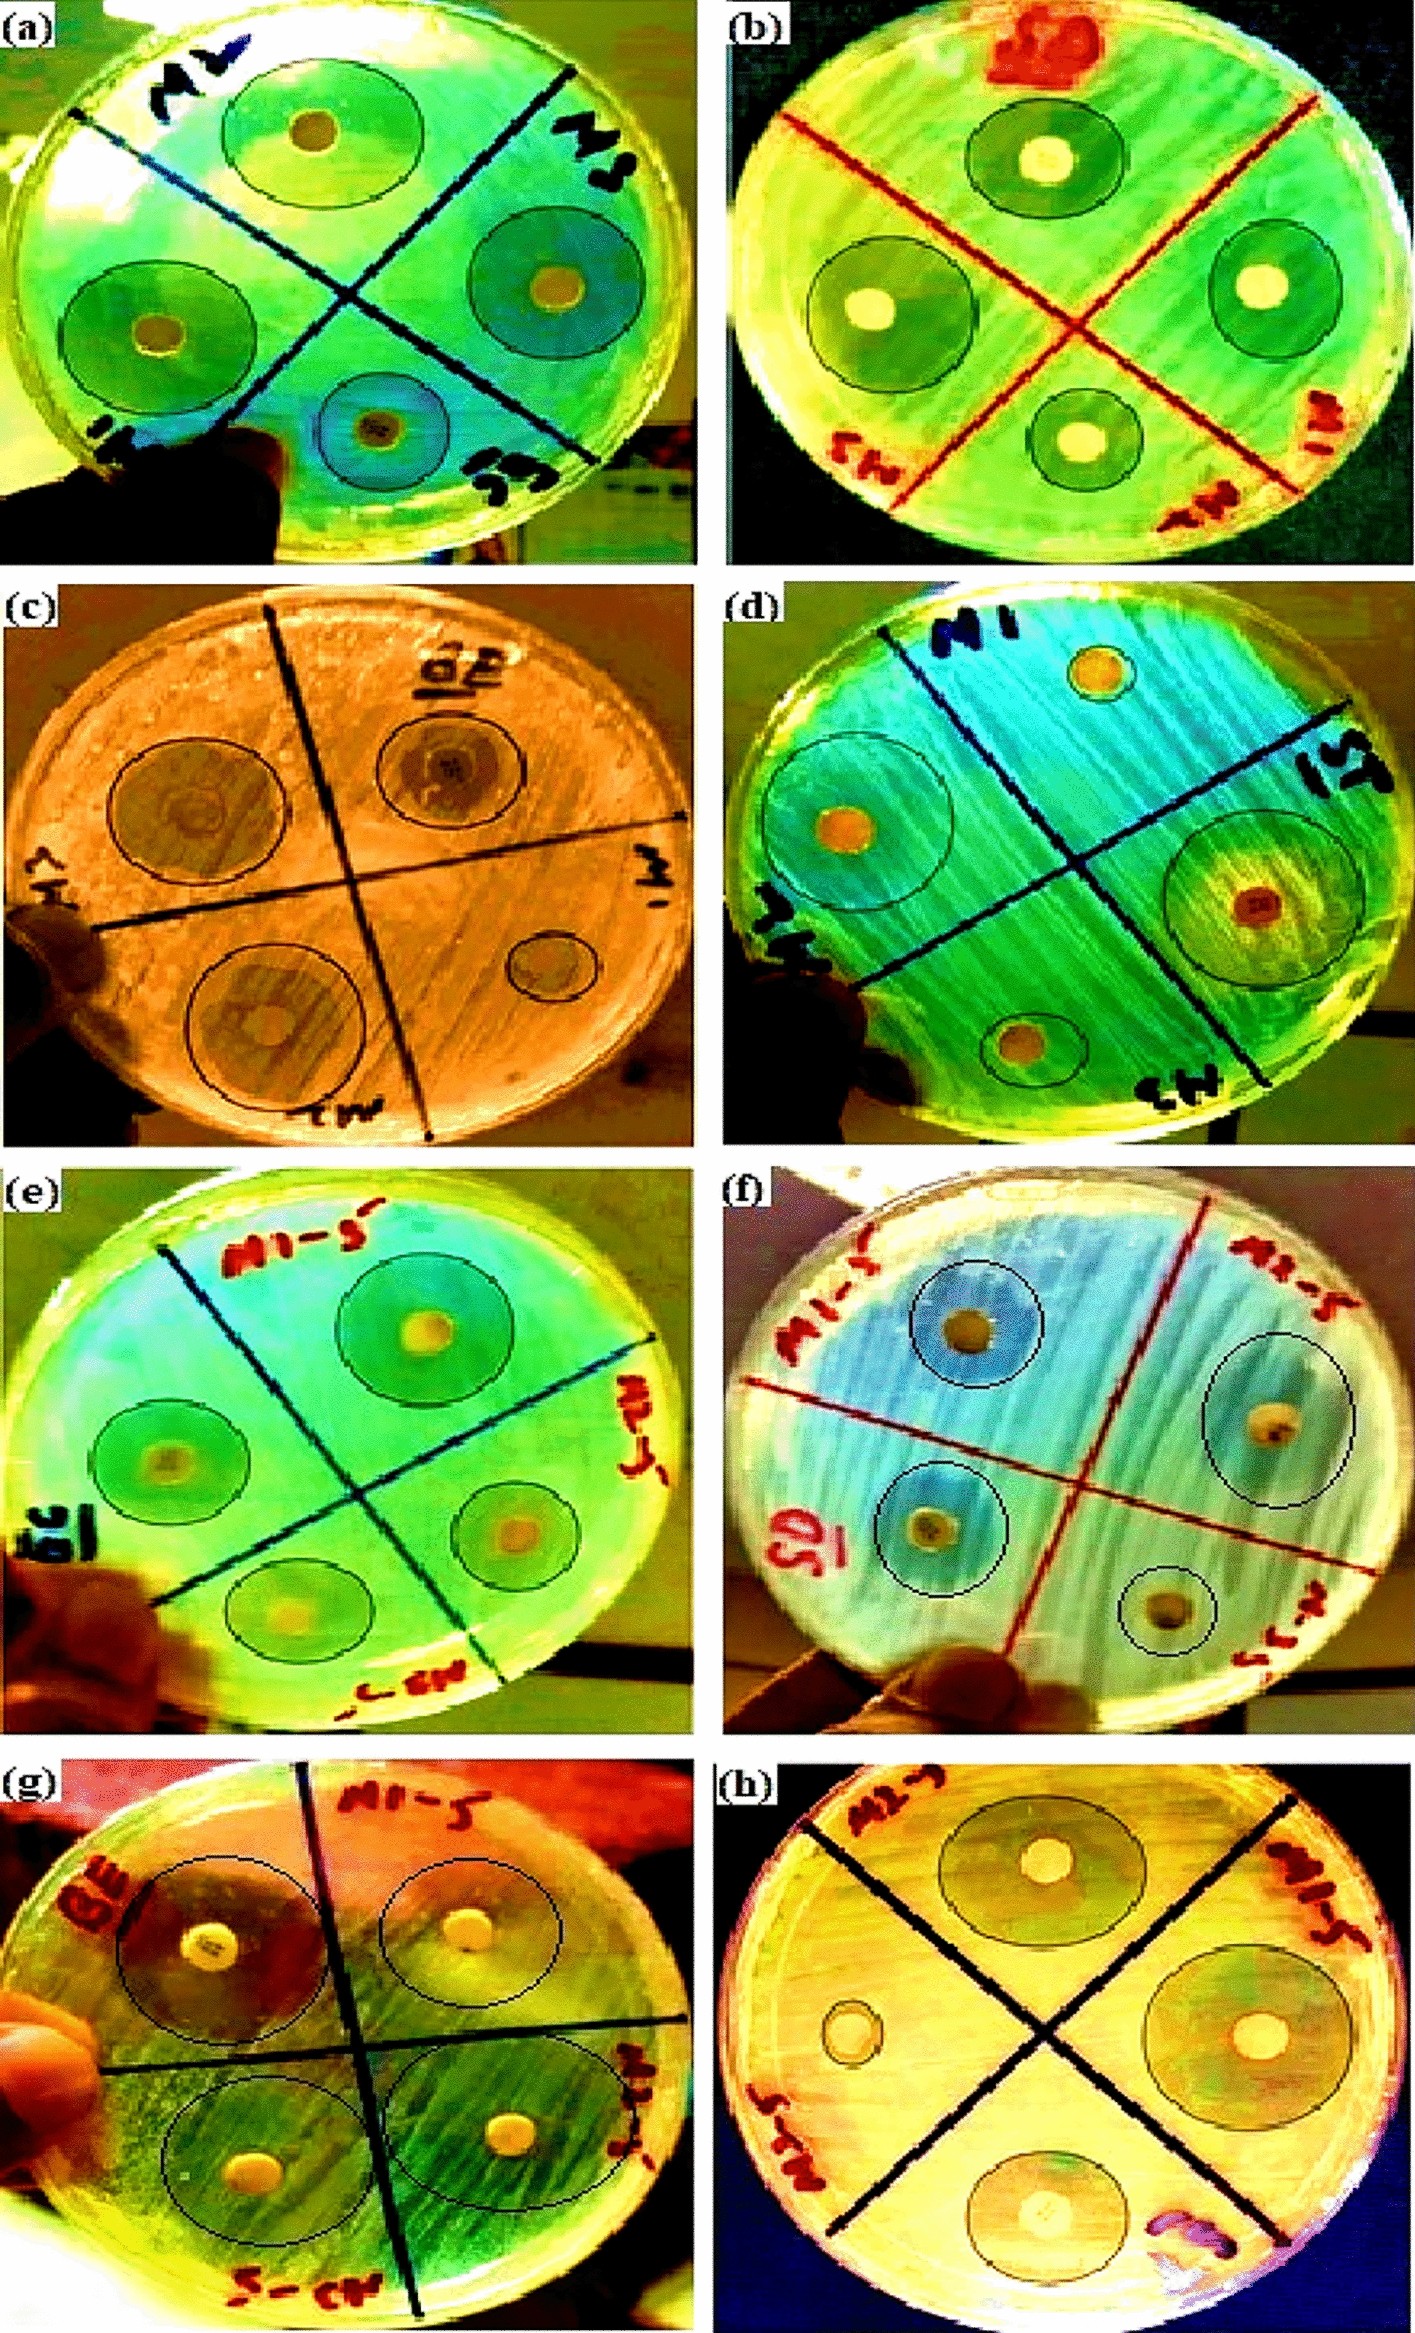
Figure 7

Figure 7
Clear inhibition zones are shown by PCL-Hb particles on different bacterial strains. (a) E.coli, (b) Pseudomonas, (c) Bacillus cereus, and (d) Staphylococcus aureus had shown the results for PCL-Hb1%PVA (S1) where M1, M2, and M3 represented different particles concentrations on each bacteria. Similarly, (e), (f), (g), and (h) have shown the results for PCL-Hb5% PVA (S5) on the same bacterial strains, and concentrations were represented by M1-5, M2-5, and M3-5.